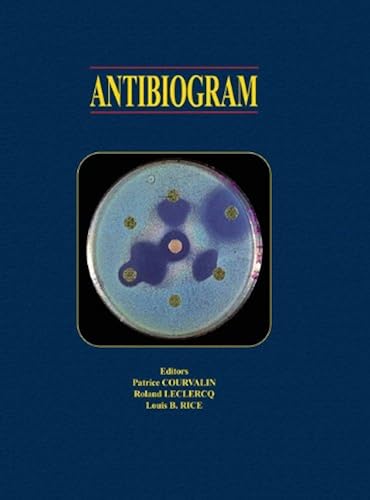
Download Antibiogram PDF

[Télécharger] Antibiogram de Patrice Courvalin Livres Pdf Epub
Télécharger Antibiogram de Patrice Courvalin Francais PDF
Télécharger "Antibiogram" de Patrice Courvalin livre En ligne
Auteur : Patrice Courvalin
Catégorie : Livres anglais et étrangers,Science,Biological Sciences
Broché : * pages
Éditeur : *
Langue : Français, Anglais
Explores the new categories of antibiotics and the numerous forms of resistance over the last 20 years. Provides a unique, comprehensive compendium for antibiotherapy. Includes expanded coverage of new categories of antibiotics. Presents appendixes that include everything from definitions and acronyms to information on industry Websites and other applicable literature. Co-published with Editions ESKA. This title is published by the American Society of Microbiology Press and distributed by Taylor and Francis in rest of world territories.
Télécharger Antibiogram de Patrice Courvalin Pdf Ebook
Télécharger Antibiogram Livre PDF Online Francais 0944 ~ Antibiogram D'autres petits sites pour télécharger des ebooks gratuits en bonus Antibiogram Télécharger vos Ebooks Gratuitement en libre partage en format EPUB, PDF et utiliser votre lisseuse préférée pour les lire. Livres électroniques gratuits. Antibiogram Résultats Web Antibiogram - broché - R. Leclercq, P . - livre.fnac .
Télécharger De l'antibiogramme ã la prescription PDF Livre ~ Télécharger Apprenez ã observer 40 animaux faciles ã voir en forãªt : Toutes les astuces de terrain pour observer; saison par saison; les animaux de nos forãªts PDF Livre Télécharger Apprentissage de l'écriture et psychomotricité PDF Livre
Brand: Difusion Grammatica basica del estudiante de ~ Brand: Difusion est un livre intitulé Grammatica basica del estudiante de espanol : A1-B1 avec la catégorie Livres en langues étrangères. Télécharger maintenant ou lire le livre Grammatica basica del estudiante de espanol : A1-B1 en ligne gratuit sous la forme de fichiers PDF et ePUB! Les détails suivants sur le livre: Titre livre :…
[ Livre PDF ] (PDF) Télécharger PDF : Brand Content ~ (PDF) Télécharger PDF : Brand Content – Comment Les Marques Se Transforment en Medias , – version PDF. La publicité classique va disparaitre ! Nous sommes entrés dans une période de mutation et le brand content (création de contenus par les marques) va prendre le relais. Objectif communiquer autrement. Les marques ne se contentent .
Brand: W W Norton Company Self–Renewal – The Individual ~ Brand: W W Norton Company est un livre intitulé Self–Renewal – The Individual & the Innovative Society (Paper) avec la catégorie History. Télécharger maintenant ou lire le livre Self–Renewal – The Individual & the Innovative Society (Paper) en ligne gratuit sous la forme de fichiers PDF et ePUB! Les détails suivants sur le livre: Titre…
Télécharger les ebooks gratuits de Droit ~ Liste complète des livres de Droit à télécharger gratuitement Ebooks en format .epub et .pdf.
Booksmart : le logiciel de création de livre gratuit ~ Créez un livre avec BookSmart, l'outil de fabrication de livres gratuit et facile à utiliser de Blurb. Téléchargement gratuit pour Mac et PC
EBOOKS GRATUITS Télécharger .epub et .pdf ~ Télécharger des ebooks gratuits. Le plus grand site de téléchargement gratuit de livres électroniques en français. Retrouvez facilement le livre que vous recherchez dans notre base de données et téléchargez-le gratuitement en format.epub,.pdf ou achetez-le sur Amazon. Nous avons la plus grande liste gratuite d’ebooks sur Internet, avec plus de 200.000 livres. Vous pouvez .
Télécharger Ebook Favorite brand name barbecue collection ~ Télécharger PDF Favorite brand name barbecue collection par par - gratuit. Livres PDF gratuit par par -. Normalement, ce livre vous a coûté EUR 27,59. Ici, vous pouvez télécharger ce livre gratuitement au format PDF sans avoir à dépenser davantage. Télécharger en illimité des ebooks, romans et livres en format EPUB, PDF gratuitement sur le N°1 des sites de ebooks gratuit. Cliquez .
Télécharger Brave / Brave Browser ~ Télécharger Brave. Le nouveau navigateur Brave bloque les publicités et les traqueurs qui vous ralentissent et qui envahissent votre vie privée. Télécharger Brave. Cette version de Brave peut être téléchargée pour Windows 64-bit, Windows 32-bit, macOS et Linux. Naviguez jusqu’à 3 fois plus vite . Bloquez les annonces et les traqueurs qui vous suivent partout. Recevez des .
[ Livre PDF ] Télécharger : Brand Content - Comment Les ~ Télécharger : Brand Content – Comment Les Marques Se Transforment en Medias en PDF. Ce livre expose ce phénomène émergeant, en montre la cohérence, expose ses règles de fonctionnement et les conséquences pour la gestion des marques. La publicité classique va disparaitre ! Nous sommes entrés dans une période de mutation et le brand .
Russell Banks : tous les livres / fnac ~ Télécharger Outer Banks - ebook (ePub) Three Early Novels. Russell Banks. 1 conte de noël OFFERT 8 €99. Voir plus Les univers. Livres DVD Blu Ray voir aussi. Livre Roman et Nouvelles Romans et récits de voyage Meilleures ventes roman de voyage; Livre Rentrée universitaire Poésie, Théâtre, Lettres .
De l'antibiogramme à la prescription de François Jehl ~ Télécharger Télécharger. Voir toute la sélection . Les clients ont également aimé. 35,00 € Commander Ajouter au panier. 69,00 € Commander Ajouter au panier. 69,00 € Commander Ajouter au panier. 39,00 € Commander Ajouter au panier. 34,90 € Commander Ajouter au panier. 15,00 € Commander Ajouter au panier. Derniers produits consultés. De l'antibiogramme à la prescription est .
Brand: Portfolio The Ultimate Sales Machine: Turbocharge ~ Brand: Portfolio est un livre intitulé The Ultimate Sales Machine: Turbocharge Your Business with Relentless Focus on 12 Key Strategies avec la catégorie Production & Operations. Télécharger maintenant ou lire le livre The Ultimate Sales Machine: Turbocharge Your Business with Relentless Focus on 12 Key Strategies en ligne gratuit sous la forme de fichiers PDF…
TÉLÉCHARGER PAPAS BURGERIA GRATUIT ~ TÉLÉCHARGER PAPAS BURGERIA GRATUIT - Scannez le code QR et installez cette application directement sur votre appareil Android. In this brand-new edition of Papa's Burgeria, you are
Brand: Pearson Education Canada Buzan's Study Skills: Mind ~ Brand: Pearson Education Canada est un livre intitulé Buzan's Study Skills: Mind Maps, Memory Techniques, Speed Reading and More!- avec la catégorie Memory Improvement. Télécharger maintenant ou lire le livre Buzan's Study Skills: Mind Maps, Memory Techniques, Speed Reading and More!- en ligne gratuit sous la forme de fichiers PDF et ePUB!
Ian Rankin : tous les livres / fnac ~ Télécharger The Dark Remains - ebook (ePub) William Mcilvanney Ian . The Brand New Must-Read Rebus Thriller. Ian Rankin. 1 conte de noël OFFERT 10 €99. Ajouter au panier In a house of lies - broché. Ian Rankin-5% avec retrait magasin 8 €95. 3 neufs à 8€95 4 occasions dès 5€15 Télécharger Rebus: The Early Years - ebook (ePub) Knots And Crosses, Hide And Seek and Tooth And Nail .
Brand: Green Books The Transition Handbook: From Oil ~ Brand: Green Books est un livre intitulé The Transition Handbook: From Oil Dependency to Local Resilience avec la catégorie Oil & Energy. Télécharger maintenant ou lire le livre The Transition Handbook: From Oil Dependency to Local Resilience en ligne gratuit sous la forme de fichiers PDF et ePUB! Les détails suivants sur le livre: Titre…
Beedeez Training – Applications sur Google Play ~ L’application de Mobile Learning Beedeez Training permet aux entreprises d’offrir à leurs collaborateurs des formations professionnelles innovantes, mobiles et intuitives ! Tout a été conçu afin d’optimiser l’ancrage des connaissances sur le long terme : - Les capsules sont courtes et diversifiées (texte, vidéo, image) - Les formats sont ludiques : les meilleurs mécanismes de .
Livres Gratuits - Free Books - كتب مجانية - Home / Facebook ~ Livres Gratuits - Free Books - كتب مجانية. 45,905 likes · 25 talking about this. FreeBook est un espace pour la vente des livres partout au Maroc, et pour le partage des livres en PDF gratuitement
Brand: Pariyatti Publishing The Noble Eightfold Path: Way ~ Brand: Pariyatti Publishing est un livre intitulé The Noble Eightfold Path: Way to the End of Suffering Télécharger maintenant ou lire le livre The Noble Eightfold Path: Way to the End of Suffering en ligne gratuit sous la forme de fichiers PDF et ePUB! Les détails suivants sur le livre: Titre livre : The Noble…
Cadillac Voiture télécharger gratuitement le manuel d ~ Cadillac Voiture télécharger gratuitement le manuel d’utilisateur. Nous vous suggérons d’obtenir un manuel d’utilisateur pour tous les types de Cadillac Voiture. Sélectionnez le guide d'utilisateur pour votre Cadillac Voiture. Partager la page. Share; Plus; Tweet; Envoyer un email; Copier le lien ; code BB Lien direct Cadillac 2011 Escalade Manuel d'utilisateur 6.32 Mb 558 pages 2269 .
TÉLÉCHARGER PIZAP PHOTO 2011 GRATUIT ~ TÉLÉCHARGER PIZAP PHOTO 2011 GRATUIT - Contact Manager free Logiciel Windows. Si vous cherchez un logiciel gratuit à telecharger ou un logiciel libre c'est sur le logiciel gratuit qu'il faut
Amazon - Effondrement: Comment les sociétés décident de ~ Noté /5. Retrouvez Effondrement: Comment les sociétés décident de leur disparition ou de leur survie et des millions de livres en stock sur Amazon. Achetez neuf ou d'occasion
Télécharger à couper le souffle livre pdf Gratuit Michael ~ Télécharger à couper le souffle livre pdf Gratuit Michael Webb October 20 · Bien sûr, peut-être vous ne pouvez même pas emballé était un petit livre gratuit de coupe nerveux souffle l'idée d'une caresse buccale lui, mais les faits sont là: votre capacité à leurs s exceptionnelles en font un point la force fondamentale de la relation avec votre mari.
Post a Comment for "[Télécharger] Antibiogram de Patrice Courvalin Livres Pdf Epub"